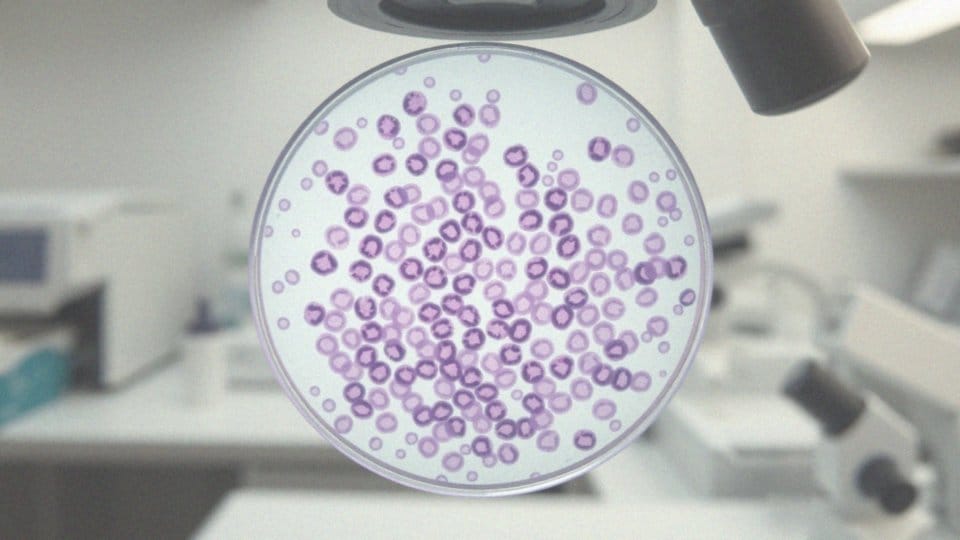

Spis treści
Co to jest test p16/Ki67?
Test p16/Ki-67 to specjalistyczne badanie immunohistochemiczne, które ocenia ekspresję dwóch kluczowych białek: p16 i Ki-67 w komórkach szyjki macicy. Ekspresja białka p16 jest typowa dla komórek zainfekowanych wirusem HPV, zwłaszcza tych uznawanych za wysokiego ryzyka. Wzrost poziomu p16 może sugerować możliwość przekształcenia nowotworowego oraz stany przedrakowe, podczas gdy białko Ki-67 pełni rolę wskaźnika proliferacji komórkowej, co świadczy o częstotliwości podziałów komórkowych.
Pozytywny rezultat testu p16/Ki-67 wskazuje na zaburzenia w cyklu komórkowym, co często jest związane z przewlekłą infekcją wirusem HPV, a to z kolei zwiększa ryzyko rozwoju raka szyjki macicy. Badanie to jest niezwykle istotne w różnicowaniu łagodnych zmian od nowotworowych oraz w ocenie ryzyka postępu patologicznych zmian. Test p16/Ki-67 odgrywa kluczową rolę w diagnostyce raka szyjki macicy, ponieważ pozwala na szybsze zidentyfikowanie pacjentek, które mogą wymagać bardziej zaawansowanego leczenia.
Ponadto, jest również wykorzystywane do monitorowania pacjentek, u których wcześniej zdiagnozowano nowotwory. Jego znaczenie diagnostyczne polega na zdolności wykrywania niepokojących zmian, które mogłyby umknąć podczas standardowych badań cytologicznych.
Kto powinien wykonać badanie p16/Ki67?
Badanie p16/Ki67 powinno zostać przeprowadzone u pacjentek z niejednoznacznymi wynikami cytologii ginekologicznej. Dotyczy to takich wyników jak:
- ASC-US, czyli atypowe komórki płaskonabłonkowe o nieokreślonym znaczeniu,
- LSIL, które wiążą się z małymi zmianami śródnabłonkowymi.
Jest to również zalecane w sytuacjach, gdy istnieje podejrzenie o zmiany onkogenne związane z wirusem HR-HPV. Szybkie wykonanie badania p16/Ki67 ma ogromne znaczenie, ponieważ pozwala ocenić ryzyko rozwoju raka szyjki macicy. Test ten wspiera również decyzje o dalszych badaniach, takich jak kolposkopia czy histopatologia. Zlecenia badania dokonuje lekarz ginekolog, który ocenia konieczność testu na podstawie wyników cytologicznych oraz historii zdrowia pacjentki. Dzięki tej procedurze, p16/Ki67 staje się niezwykle istotnym narzędziem w diagnostyce u kobiet, które mają niepokojące wyniki.
Dlaczego badanie immunohistochemiczne jest ważne w diagnostyce raka szyjki macicy?
Badanie immunohistochemiczne pełni fundamentalną rolę w wykrywaniu raka szyjki macicy. Daje możliwość dokładnego rozróżnienia pomiędzy zmianami, które są łagodne, a tymi nowotworowymi na poziomie komórkowym. Dzięki wykorzystaniu przeciwciał p16 oraz anty-Ki67, lekarze mogą wcześniej identyfikować nowotwory oraz stany przedrakowe, co jest kluczowe dla skuteczności terapii. Analiza ta ujawnia ekspresję białka p16, które związane jest z infekcją wirusem HPV oraz potencjalnymi zmianami nowotworowymi.
Dodatkowo, monitoruje się białko Ki-67, które stanowi wskaźnik proliferacji komórek. Z danych statystycznych wynika, że wczesne wykrycie nieprawidłowych zmian w szyjce macicy istotnie zwiększa szanse na pomyślne leczenie. Z tego powodu badanie to okazuje się niezwykle cenne.
- wysoka ekspresja zarówno p16, jak i Ki-67 może sugerować ryzyko rozwoju nowotworu,
- analiza tych białek umożliwia lekarzom podjęcie właściwych działań diagnostycznych i terapeutycznych,
- działania te przyczyniają się do polepszenia wyników leczenia oraz zmniejszenia ryzyka zaawansowania choroby.
Jakie inne metody diagnostyczne wspierają badanie p16/Ki67?
Badanie p16/Ki-67 zyskuje na znaczeniu w procesie diagnostyki. Dzięki plejadzie różnorodnych technik, które wspierają jego interpretację, lekarze mogą dokładniej ocenić zdrowie pacjentek. Wśród tych metod wyróżnia się:
- cytologia ginekologiczna,
- nowoczesna cytologia na podłożu płynnym (LBC),
- test HPV, który, przy szczegółowej analizie mRNA białek onkogennych E6 oraz E7 wirusa HPV, ma kluczowe znaczenie w identyfikacji nowotworów wysokiego ryzyka,
- kolposkopia uzupełniona o biopsję,
- badanie histopatologiczne, stanowiące ostatni etap diagnostyki.
Kolejną ważną metodą w diagnostyce jest kolposkopia uzupełniona o biopsję. To technika, która pozwala na pobieranie próbek tkankowych do dalszej analizy histopatologicznej, co umożliwia szczegółowe zbadanie zmian. Badanie histopatologiczne dostarcza cennych informacji na temat charakterystyki tych nieprawidłowości. Wiedza ta jest niezbędna dla skutecznego prowadzenia terapii. Wszystkie wymienione metody działają w synergii z wynikami analizy p16/Ki-67, uzgadniając biomechanizmy zmian komórkowych z ogólnym kontekstem klinicznym. Taka integracja informacji pozwala specjalistom na kompleksową ocenę ryzyka rozwoju raka szyjki macicy. Dzięki temu lekarze są w stanie podejmować trafniejsze decyzje terapeutyczne. Zastosowanie zintegrowanego podejścia do diagnostyki zapewnia wysoką jakość oceny oraz efektywniejsze leczenie nowotworów szyjki macicy.
Jakie zmiany cytologiczne mogą wskazywać na potrzebę badania p16/Ki67?
Cytologiczne zmiany, które mogą wskazywać na potrzebę wykonania badania p16/Ki-67, obejmują nieprawidłowe wyniki w badaniach ginekologicznych, takie jak:
- ASC-US, czyli atypowe komórki płaskonabłonkowe o nieokreślonym znaczeniu,
- LSIL, czyli zmiany śródnabłonkowe małego stopnia.
Oba te wyniki mogą świadczyć o obecności komórek związanych z ryzykiem stanów przedrakowych lub rakiem szyjki macicy. W przypadku stwierdzenia ASC-US niezwykle ważne jest podjęcie dalszej diagnostyki, ponieważ tego rodzaju zmiany mogą być efektem infekcji wirusem HPV, który zwiększa ryzyko rozwoju nowotworów. Na przykład, jeśli wynik wskazuje na LSIL, wskazane jest przeprowadzenie badania p16/Ki-67, aby określić ewentualne ryzyko transformacji nowotworowej. Podwyższona ekspresja białek p16 oraz Ki-67 może świadczyć o pojawiających się zmianach nowotworowych. Taka informacja pozwala na szybsze podjęcie działań medycznych oraz wczesne rozpoczęcie leczenia, co jest szczególnie istotne dla zdrowia pacjentek.
Jakie zmiany nowotworowe można wykryć dzięki badaniu p16/Ki67?
Badanie p16/Ki-67 odgrywa kluczową rolę w rozpoznawaniu nowotworów szyjki macicy. Dzięki niemu można wychwycić nieprawidłowości w cyklu komórkowym, co często wskazuje na rozwój procesu nowotworowego. Pozytywny wynik tego testu sugeruje obecność komórek z nieprawidłową ekspresją białek p16 oraz Ki-67. Zmiany te są zazwyczaj związane z infekcją wirusem HR-HPV, który zwiększa ryzyko wystąpienia raka u kobiet.
Wyniki badania mogą ujawniać różne etapy zmian nowotworowych, w tym przedrakowe stany, takie jak:
- CIN, czyli neoplazja śródnabłonkowa szyjki macicy,
Wczesne wykrycie tych nieprawidłowości ma ogromne znaczenie, gdyż umożliwia podjęcie odpowiednich działań terapeutycznych jeszcze przed rozwinięciem się nowotworu. Test p16/Ki-67 stanowi cenne wsparcie dla lekarzy w ocenie ryzyka oraz w prewencji progresji choroby. Wysoka ekspresja zarówno p16, jak i Ki-67 jest wyraźnym sygnałem do dalszych badań i regularnego monitorowania stanu zdrowia pacjentki. Dlatego też badanie p16/Ki-67 jest nieocenione w dokładnej diagnostyce raka szyjki macicy oraz ocenie potencjalnych zagrożeń onkologicznych.
Co oznacza dodatni wynik testu p16/Ki67?
Dodatni wynik testu p16/Ki-67 wskazuje na nieprawidłową ekspresję białek p16 oraz Ki-67, co może świadczyć o problemach z cyklem komórkowym. Takie rezultaty często wiążą się z przewlekłą infekcją wirusem HR-HPV, który odgrywa kluczową rolę w rozwoju raka szyjki macicy.
Białko p16 jest typowe dla komórek zainfekowanych tym wirusem, natomiast Ki-67 wskazuje na aktywność proliferacyjną komórek. Ważne jest, aby pamiętać, że pozytywna ekspresja tych białek nie oznacza bezpośrednio nowotworu. Niemniej jednak, sygnalizuje ona wyższe ryzyko przekształceń nowotworowych.
Wysoki poziom obu białek może wskazywać na potencjalne zmiany onkogenne. Dlatego konieczne jest przeprowadzenie dodatkowych badań, takich jak:
- kolposkopia,
- biopsja.
Te badania pozwolą dokładniej ocenić stan zdrowia pacjentki. Szybkie potwierdzenie nieprawidłowości umożliwia wprowadzenie skuteczniejszych działań terapeutycznych, co może istotnie poprawić rokowania. Ten wynik podkreśla, jak ważne jest wczesne wykrywanie i monitorowanie ewentualnych zmian nowotworowych.
Jak interpretować wynik pozytywny na obecność markerów p16/Ki67?
Interpretacja pozytywnego wyniku testu p16/Ki67 odgrywa kluczową rolę w diagnozowaniu raka szyjki macicy. Taki rezultat wskazuje na nieprawidłową ekspresję białek p16 oraz Ki-67, co może sygnalizować patologiczne zmiany w komórkach. Te zmiany mogą z kolei przyczynić się do rozwoju nowotworu, często powiązanego z infekcją wirusem HPV, który jest istotnym czynnikiem ryzyka.
Po otrzymaniu dodatniego wyniku niezbędne jest wykonanie kolejnych badań, takich jak:
- kolposkopia z biopsją,
- precyzyjniejsza ocena zmian w szyjce macicy,
- ocena zaawansowania zmian.
Informacje uzyskane podczas kolposkopii są kluczowe dla lekarzy, pomagając w podejmowaniu właściwych decyzji dotyczących leczenia. Wynik pozytywny testu p16/Ki67 może również sugerować obecność stanów przedrakowych, jak neoplazja śródnabłonkowa (CIN). Ważne jest, aby szybko zareagować na taki wynik i regularnie monitorować pacjentki, co pozwala na błyskawiczne podejmowanie decyzji o terapii.
Takie proaktywne podejście umożliwia wczesną interwencję, co ma znaczący wpływ na poprawę prognoz zdrowotnych. Systematyczne kontrole wyników oraz odpowiednie działania diagnostyczne znacząco zwiększają szanse na efektywne leczenie zmian nowotworowych związanych z szyjką macicy.
Jakie są potencjalne konsekwencje dodatniego wyniku testu p16/Ki67?
Dodatni wynik testu p16/Ki-67 ma znaczący wpływ na zdrowie pacjentki, co podkreśla potrzebę przeprowadzenia dalszych badań diagnostycznych. W tym przypadku istotnymi procedurami są:
- kolposkopia,
- biopsja – umożliwiają precyzyjną ocenę stanu szyjki macicy.
Pozwalają one na sprawdzenie, czy w tkankach występują stany przedrakowe bądź jakiekolwiek formy raka szyjki macicy. Gdyby wyniki wskazywały na nieprawidłowości, mogłoby to oznaczać konieczność wdrożenia leczenia. W takim wypadku można rozważyć, na przykład, chirurgiczne usunięcie zmian poprzez konizację szyjki macicy – jest to krok mający na celu zatrzymanie potencjalnego rozwoju nowotworu oraz ochronę zdrowia pacjentki.
W przypadku bardziej zaawansowanych zmian medycy mogą zaproponować inne metody terapeutyczne, takie jak:
- radioterapia,
- chemioterapia.
Ignorowanie dodatniego wyniku testu naraża pacjentkę na ryzyko przekształcenia stanu przedrakowego w pełnoobjawową chorobę nowotworową, co może prowadzić do poważnych konsekwencji zdrowotnych, w tym ryzyka inwazyjnego raka szyjki macicy. Z tego względu wczesne zdiagnozowanie problemu oraz odpowiednie terapie mają kluczowe znaczenie dla zwiększenia szans na wyleczenie oraz poprawy jakości życia pacjentek.
Jakie znaczenie ma ekspresja białek p16 i Ki-67?

Ekspresja białek p16 oraz Ki-67 ma fundamentalne znaczenie w ocenie ryzyka rozwoju raka szyjki macicy. Wysoki poziom p16 jest wskazówką obecności stanów przedrakowych, szczególnie w kontekście infekcji wirusem HR-HPV. Natomiast białko Ki-67 pełni rolę markera proliferacji komórkowej, wskazując na dynamikę podziału komórek, co często towarzyszy procesom nowotworowym.
Przeprowadzanie badań dotyczących ekspresji tych dwóch białek sprzyja wczesnemu wykrywaniu nieprawidłowości, co ma kluczowe znaczenie dla skuteczności leczenia. Wysoka ekspresja zarówno p16, jak i Ki-67 może sugerować konieczność przeprowadzenia dodatkowych badań, takich jak:
- kolposkopia,
- biopsja.
Analiza tych markerów nowotworowych staje się również istotnym elementem monitorowania pacjentek, u których wcześniej zidentyfikowano zmiany. Dzięki temu można ograniczyć ryzyko progresji nowotworowej oraz zwiększyć efektywność terapii. W rezultacie badanie p16/Ki-67 zyskuje na wartości jako ważne narzędzie diagnostyczne w kontekście raka szyjki macicy, umożliwiając odróżnienie zmian łagodnych od nowotworowych. Jego rola staje się jeszcze bardziej istotna w aspekcie prewencji oraz wczesnego wykrywania nowotworów. Zrozumienie wzorców ekspresji tych białek pozwala lekarzom na podejmowanie bardziej trafnych decyzji w kwestii terapii, co przekłada się na korzystniejsze rokowania dla pacjentek.



